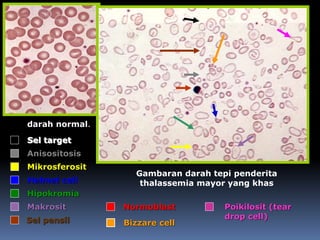
darah normal.
Gambaran darah tepi penderita
thalassemia mayor yang khas
Hipokromia
Anisositosis
Poikilosit (tear
drop cell)
Sel target
Bizzare cell
Normoblast
Helmet cell
Makrosit
Mikrosferosit
Sel pensil

Dokumen ini adalah laporan kasus seorang anak laki-laki berusia 5 tahun dengan thalasemia beta mayor, yang dirawat di RSUD Kota Bekasi. Pasien mengalami demam, lemah, dan gejala gastrointestinal, serta memiliki riwayat transfusi darah sebelumnya. Penatalaksanaan yang dilakukan meliputi penjelasan mengenai kondisi, skrining genetik, dan diet, serta pengobatan untuk mengelola anemia.